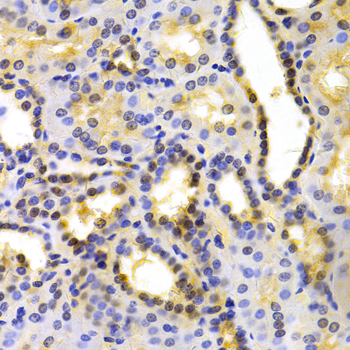
A5449: image 2

For quotations, please use our online quotation form, and you may also contact us by
sales@neoscientific.com
+1-888.733.6849
+1-617.299.7367 (Int’l)
+1-888.733.6849
+1-617.299.7367 (Int’l)
| Reactivity | Human Mouse Rat |
| Tested applications | WB IHC IF |
| Recommended Dilution | WB 1:500 - 1:2000 IHC 1:50 - 1:200 IF 1:50 - 1:200 |
| Calculated MW | 81kDa |
| Observed MW | Refer to Figures |
| Immunogen | Recombinant protein of human KIF2C |
| Storage Buffer | Store at -20℃. Avoid freeze / thaw cycles. Buffer: PBS with 0.02% sodium azide, 50% glycerol, pH7.3. |
| Synonym | MCAK; KNSL6; |

Western blot analysis of extracts of various cell lines, using KIF2C antibody.
Immunohistochemistry of paraffin-embedded human kidney using KIF2C antibody at dilution of 1:100 (x400 lens).

Immunofluorescence analysis of U20S cell using KIF2C antibody. Blue: DAPI for nuclear staining.

Immunofluorescence analysis of A549 cell using KIF2C antibody. Blue: DAPI for nuclear staining.
The protein encoded by this gene is a member of kinesin-like protein family. Proteins of this family are microtubule-dependent molecular motors that transport organelles within cells and move chromosomes during cell division. This protein is important for anaphase chromosome segregation and may be required to coordinate the onset of sister centromere separation.
N/A